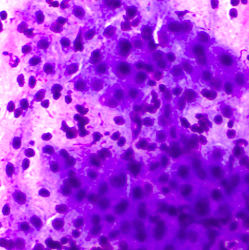
cytocore diacor srbija biopsija mekih tkiva uzorkovanje

STANDARDNA FNS
CYTOCORE
Kompatibilan sa bilo kojom tankom iglom
Dizajniran da prikuplja više ćelijskog materijala
Pluća, limfni čvor, stitna žlezda
Rotirajuće kretanje skuplja velike grupe nataknutih ćelija
Manja invazivnost, kraći postupak. Sprečava ponavljanje procedure
Konstruisan da se izvodi jednom rukom
© DIACOR - Sva prava zadržana